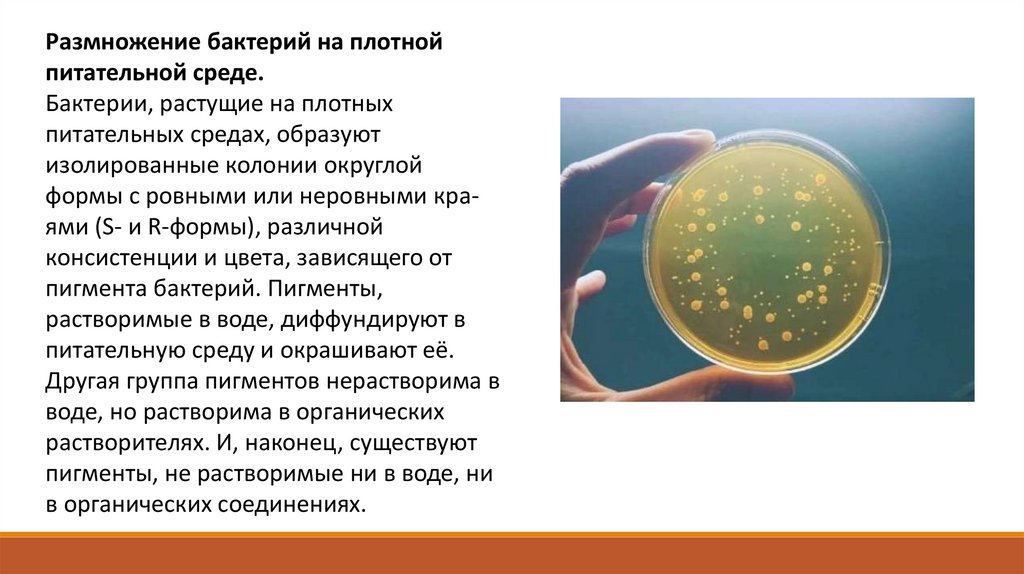

Похожие презентации:
Размножение и рост бактерий. Виды микроскопии. Описание микробиологических препаратов
1. Медицинский колледж КФУ им. В.И.Вернадского
Презентация на тему:Размножение и рост бактерий. Виды микроскопии.
Описание микробиологических препаратов.
2. Рост и размножение бактерий. Жизнедеятельность бактерий характеризуется: • ростом - формированием структурно-функциональных
Рост и размножение бактерий.Жизнедеятельность бактерий характеризуется:
• ростом - формированием структурнофункциональных компонентов клетки и
увеличением самой бактериальной
клетки
• размножением - самовоспроизведением,
приводящим к увеличению количества
бактериальных клеток в популяции.
3.
Бактерииразмножаются путем
бинарного деления пополам,
реже путем почкования.
Грамположительные бактерии
делятся путем врастания
синтезирующихся перегородок
деления внутрь клетки, а
грамотрицательные — путем
перетяжки, в результате
образования гантелевидных
фигур, из которых образуются
две одинаковые клетки.
Делению клеток
предшествует репликация
бактериальной хромосомы по
полуконсервативному типу
(двуспиральная цепь ДНК
раскрывается и каждая нить
достраивается комплементарной
нитью), приводящая к удвоению
молекул ДНК бактериального
ядра — нуклеоида.
4.
5.
Размножение бактерий в жидкой питательной среде.Бактерии, засеянные в определенный, не изменяющийся
объем питательной среды, размножаясь, потребляют
питательные элементы, что приводит в дальнейшем к
истощению питательной среды и прекращению роста
бактерий. Культивирование бактерий в такой системе
называют периодическим культивированием, а культуру —
периодической. Если же условия культивирования
поддерживаются путем непрерывной подачи свежей
питательной среды и оттока такого же объема культуральной
жидкости,
то
такое
культивирование
называется
непрерывным, а культура — непрерывной.
6.
7.
При выращивании бактерий на жидкой питательной среде наблюдается придонный, диффузный илиповерхностный (в виде пленки) рост культуры. Рост периодической культуры бактерий,
выращиваемых на жидкой питательной среде, подразделяют на несколько фаз, или периодов:
1. лаг-фаза;
2. фаза логарифмического роста;
3. фаза стационарного роста,
или максимальной концентрации
бактерий;
4. фаза гибели бактерий.
Эти фазы можно изобразить
графически в виде отрезков кривой размножения бактерий,
отражающей зависимость
логарифма числа живых клеток
от времени их культивирования.
8.
Лаг-фаза — период между посевом бактерий и началом размножения.Продолжительность лаг-фазы в среднем 4—5 ч. Бактерии при этом
увеличиваются в размерах и готовятся к делению; нарастает количество
нуклеиновых кислот, белка и других компонентов.
Фаза логарифмического (экспоненциального) роста является периодом интенсивного деления бактерий. Продолжительность ее около 5— 6 ч. При
оптимальных условиях роста бактерии могут делиться каждые 20—40 мин. Во
время этой фазы бактерии наиболее ранимы, что объясняется высокой
чувствительностью компонентов метаболизма интенсивно растущей клетки к
ингибиторам синтеза белка, нуклеиновых кислот и др.
Затем наступает фаза стационарного роста, при которой количество жизнеспособных клеток остается без изменений, составляя максимальный уровень
(М-концентрация). Ее продолжительность выражается в часах и колеблется в
зависимости от вида бактерий, их особенностей и культивирования.
Завершает процесс роста бактерий фаза гибели, характеризующаяся
отмиранием бактерий в условиях истощения источников питательной среды и
накопления в ней продуктов метаболизма бактерий. Продолжительность ее
колеблется от 10 ч до нескольких недель. Интенсивность роста и размножения
бактерий зависит от многих факторов, в том числе оптимального состава
питательной
среды,
окислительно-восстановительного
потенциала,
рН,
температуры и др.
9.
Размножение бактерий на плотнойпитательной среде.
Бактерии, растущие на плотных
питательных средах, образуют
изолированные колонии округлой
формы с ровными или неровными краями (S- и R-формы), различной
консистенции и цвета, зависящего от
пигмента бактерий. Пигменты,
растворимые в воде, диффундируют в
питательную среду и окрашивают её.
Другая группа пигментов нерастворима в
воде, но растворима в органических
растворителях. И, наконец, существуют
пигменты, не растворимые ни в воде, ни
в органических соединениях.
10.
Основными задачамимикроскопии являются
следующие:
•Выявление микроорганизмов в
различных материалах.
•Ориентировочная идентификация
микроорганизмов в образце.
•Изучение некоторых
морфологических признаков и
структур микроорганизмов
(например, капсул, жгутиков и т. д.).
•Изучение окрашенных мазков из
колоний и чистых культур.
11.
Виды микроскопии:-Светлопольная микроскопия
-Фазово-контрастная микроскопия
-Темнопольная микроскопия
-Люминесцентная (флуоресцентная)
микроскопия
-Электронная микроскопия
-Лазерная конфокальная микроскопия
-Компьютерная интерференционная
микроскопия
12.
Светлопольная микроскопия позволяет исследоватьобъекты в проходящем свете в светлом поле. Данный вид
микроскопии предназначен для исследования морфологии,
размеров клеток, их взаимного расположения, структурной
организации клеток и других особенностей. У светового
микроскопа максимальная разрешающая способность
составляет 0,2 мкм, что обеспечивает высокоточное
увеличение микроскопа до 1500х.
Фазово-контрастная микроскопия позволяет более четко
наблюдать живые прозрачные объекты, которые имеют
коэффициенты преломления, близкие к коэффициентам
преломления среды. С помощью фазово-контрастной
микроскопии изучают форму, размеры, взаимное
расположение клеток, их подвижность, размножение,
прорастание спор микроорганизмов и т. д. Благодаря
применению этого способа микроскопии контраст живых
неокрашенных микроорганизмов резко увеличивается и
они выглядят темными на светлом фоне (позитивный
фазовый контраст) или светлыми на темном фоне
(негативный фазовый контраст).
13.
Темнопольная микроскопия основана на освещенииобъекта косыми лучами света. При таком освещении лучи
не попадают в объектив, поэтому поле зрения выглядит
темным. Такое освещение препарата достигается
использованием специального темнопольного конденсора.
Темнопольная микроскопия является очень простым, но
эффективным методом и хорошо подходит для получения
изображения живых и неокрашенных биологических
образцов. Учитывая простоту установки, качество
получаемых изображений весьма хорошее.
Люминесцентная (флуоресцентная)
микроскопия основана на способности ряда веществ
биологического происхождения или некоторых
красителей светиться при их освещении невидимым
ультрафиолетовым или синим светом. При
использовании ультрафиолетового света разрешающая
способность микроскопа может достигать 0,1 мкм.
14.
Электронная микроскопия позволяет обнаружитьобъекты, которые не разрешаются при использовании
световых или ультрафиолетовых лучей.
Теоретически разрешение просвечивающего электронного
микроскопа составляет 0,002 нм; реальное разрешение
современных электронных микроскопов приближается к
0,1 нм. На практике разрешение для биологических
объектов достигает 2 нм
Лазерная конфокальная микроскопия дает возможность
получить отчетливое изображение и наблюдать объекты в
фокусе по всему полю. Данный метод пригоден лишь для
исследования самосветящихся (флуоресцентных) объектов.
15.
Компьютерная интерференционнаямикроскопия позволяет получить высококонтрастное
изображение при наблюдении субклеточных структур;
во многих случаях применяется для изучения живых
клеток. Принцип действия автоматизированного
интерференционного микроскопа основан на
интерференции световых пучков лазерного излучения,
отраженного от опорного зеркала и зеркала, на
котором помещен измеряемый фазовый объект.
Теоретически предельно достижимая разрешающая
способность может составить в среднем 0,2 нм,
практически она составляет 0,4 мкм.
16.
Научные исследования,осуществляемые учеными на
протяжении последних лет, на деле
доказывают, что применение
современных микробиологических
препаратов оказывает благотворное
влияние на процессы роста и развития
сельскохозяйственных растений как в
качественных, так и количественных
показателях, напрямую влияя на
уровень их урожайности.
17.
Дело в том, что микробиологическиепрепараты содержат различные
препаративные формы субстрата - носителя,
которые обладают способностью увеличивать
содержание сахаров во фруктах, овощах и
ягодах (в том числе в плодах винограда и
сахарной свекле). В зерновых культурах
отдельные компоненты способствуют
повышению уровня клейковины, а в
эфиромасличных растениях в подсолнечнике
увеличивают процент содержания
растительных масел.
Биологи также доказали,что использование
микробиологических средств ускоряет сроки
созревания плодов и стабилизирует их
размеры. (ред.)
18.
Описание микробиологических препаратов.•Стафилококки имеют шаровидную форму, в мазке располагаются скоплениями, напоминающиеми
гроздья винограда. По Граму окрашиваются положительно – в фиолетовый цвет.
•Стрептококки имеют шаровидную форму, в мазке располагаются цепочками, парами, небольшими
скоплениями, по Граму окрашиваются положительно – в фиолетовый цвет.
•Clostridium perfringens (возбудитель газовой гангрены), чистая культура, окраска по Граму. Крупные
палочки, расположенные одиночно, парами, небольшими цепочками, по Граму окрашиваются
положительно.
•Escherichia coli, чистая культура, окраска по Граму. Мелкие палочки с закругленными концами, в мазке
располагаются беспорядочно. По Граму окрашиваются отрицательно.
•Neisseria gonorrhoeae, окраска по Леффлеру (метиленовым синим). Мазок окрашен в синий цвет. В
поле зрения видны лейкоциты, в отдельных лейкоцитах содержится множество диплококков. Большое
количество бактерий внутри лейкоцитов указывает на незавершенный фагоцитоз.
19.
•Окраска по Граму смешанного мазка. В поле зрения видны грамположительные кокки фиолетового цвета играмотрицательные палочки красного цвета.
•Окраска мокроты больного туберкулезом по Цилю-Нильсену. В поле зрения виды рубиново-красные
кислотоустойчивые туберкулезные палочки и некислотоустойчивые бактерии и элементы мокроты, окрашенные в синий
и голубой цвет.
•Чистая культура капсульных бактерий Klebsiella pneumoniae, окраска по методу Бурри-Гинса. На темном фоне туши
видны красные бактериальные клетки, окруженные неокрашенными бесцветными капсулами.
•Дрожжеподобный гриб Сandida albicans, простой метод окраски. В поле зрения видны крупные круглые или овальные
клетки. От материнских клеток отпочковываются дочерние клетки.
•Treponema pallidum – бледная трепонема, негативное контрастирование по Бурри. На тёмном фоне видны тонкие
неокрашенные светлые нити с равномерными завитками (8-14).
•При окраске по Граму нити актиномицетов представляются, как правило, грамположительными фиолетовыми.
20.
•Actinomyces israelii становится патогенным, если он внедряется в инфицированные раны слизистой оболочки, особеннов сочетании с другими патогенными микроорганизмами. Инфекция, вызываемая Actinomyces israelii — актиномикоз
встречается редко и обычно развивается у ослабленных людей.
•Corynebacterium pseudodiphthericum, окраска по Граму. В мазках из выросших колоний, окрашенных по Граму, видны
грамположительные прямые или слегка изогнутые полиморфные палочки, располагающиеся кучками в виде
рассыпанных булавок или римской цифры V, или буквы L.
•Мазок из чистой культуры Yersinia pestis,окраска метиленовым синим. Характерной морфологической особенностью
является овоидная форма микроба, биполярная окрашиваемость. Биполярная окрашиваемость обусловлена
неравномерным распределением цитоплазмы, когда средняя часть клетки почти не окрашивается, а полюса окрашены
интенсивно. В мазках из патологического материала (мокрота, гной бубона, кровь, содержимое язв, мазки-отпечатки
органов) часто располагаются цепочками, при окраске метиленовой синькой, выявляется биполярность.
•Мазок из чистой культуры E.faecalis. Окраска по Граму. Энтерококки - сферические или овоидной формы
грамположительные бактерии, располагающиеся парами или короткими цепочками, размеры (0,6-2,0 х 0,6-2,5мкм). Спор
и капсул не образуют. Изредка обладают жгутиками. Факультативные анаэробы.
•Bacillus cereus — грамположительная, спорообразующая почвенная бактерия. Вызывает токсикоинфекции у человека.
Бациллы представлены крупными прямыми палочками, положительно окрашивающимися по Граму.
21.
•Трофозоиты лямблий имеют грушевидную форму; длина 9—21 мкм, ширина 5-15 мкм, толщина 2-4 мкм.Микроорганизмы имеют два ядра, придающие паразиту (в сочетании с параба-зальным телом) вид «лица с
гримасничающим ртом», особенно хорошо видным на окрашенных препаратах (раствор Люголя).
•Toxoplasma gondii, окраска по Романовскому-Гимзе. Тело токсоплазмы имеет полулунную или овальную форму .
Передний конец тела заострен. Размеры токсоплазм колеблются от 4 до 9 мкм в длину и от 2 до 4 мкм в ширину. При
наблюдении в обычном световом микроскопе у токсоплазм на фоне голубой цитоплазмы выделяется пузырьковидное
карминово-красное ядро. С помощью электронного микроскопа можно обнаружить, что на переднем конце тела
токсоплазмы имеется спиралевидная структура – так называемый коноид, с отходящими от него тончайшими
фибриллами (микротрубочками), выполняющими функцию двигательного аппарата.
•Plasmodium malaria, окраска по Романовскому-Гимзе. Возбудители паразитируют в эритроцитах. По РомановскомуГимзе цитоплазма паразитов окрашивается голубой цвет, ядро - в красно-фиолетовый.
22.
Список литературыhttps://studfile.net/preview/5810976/page:3/
https://studfile.net/preview/5244850/page:8/
https://studfile.net/preview/1818486/
https://agrostory.com/info-centre/knowledgelab/budushchee-prinadlezhit-mikrobiologicheskimpreparatam/

Биология
Биология








